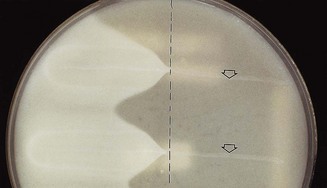
image

Chapter 13 Actinomycetes, clostridia and Bacillus species
Actinomycetes
Actinomycetes, which were formerly thought to be fungi, are true bacteria with long, branching filaments analogous to fungal hyphae. The two important genera of this group are Actinomyces and Nocardia. The chemical structure of the cell wall of these organisms is similar to that of corynebacteria and mycobacteria, and some are acid-fast. Actinomyces spp. are microaerophilic or anaerobic; Nocardia spp. are aerobic organisms.
Actinomyces spp.
Although most Actinomyces are soil organisms, the potentially pathogenic species are commensals of the mouth in humans and animals. They are a major component of dental plaque, particularly at approximal sites of teeth, and are known to increase in numbers in gingivitis. An association between root surface caries of teeth and Actinomyces has been described. Other sites colonized are the female genital tract and the tonsillar crypts.
A number of Actinomyces species are isolated from the oral cavity. These include Actinomyces israelii, Actinomyces gerencseriae, Actinomyces odontolyticus, Actinomyces naeslundii (genospecies 1 and 2), Actinomyces myeri and Actinomyces georgiae. A close relationship between Actinomyces odontolyticus and the earliest stages of enamel demineralization, and the progression of small caries lesions have been reported. The most important human pathogen is A. israelii.
Actinomyces israelii
Habitat and transmission
This organism is a commensal of the mouth and possibly of the female genital tract. It is a major agent of human actinomycosis.
Characteristics
Gram-positive filamentous branching rods. Non-motile, non-sporing and non-acid-fast. Clumps of the organisms can be seen as yellowish ‘sulphur granules’ in pus discharging from sinus tracts, or the granules can be squeezed out of the lesions. (Strains belonging to A. israelii serotype II are now in a separate species, A. gerencseriae, a common but minor component of healthy gingival flora.)
Culture and identification
Grows slowly under anaerobic conditions, on blood or serum glucose agar at 37°C. After about a week, it appears as small, creamy-white, adherent colonies on blood agar. The colonies resemble breadcrumbs or the surface of ‘molar’ teeth (Fig. 13.1). Because of the exacting growth requirements and the relatively slow growth, isolating this organism from clinical specimens is difficult, particularly because the other, faster-growing bacteria in pus specimens tend to obscure the slow-growing actinomycetes. ‘Sulphur granules’ in lesions are a clue to their presence. When possible, these granules should be crushed, Gram-stained and observed for Gram-positive, branching filaments, and also cultured in preference to pus.
Pathogenicity
Most (70–80%) actinomycotic infections are chronic, granulomatous, endogenous infections of the orofacial region (Fig. 13.2). Typically, the lesions present as a chronic abscess, commonly at the angle of the lower jaw, with multiple external sinuses. There is usually a history of trauma such as a tooth extraction or a blow to the jaw. Actinomycetes are also isolated from infections associated with intrauterine devices, but their pathogenic role is unclear.

Fig. 13.2 A histopathological section from an actinomycetic lesion of the mandible showing a branching filamentous mass of Actinomyces spp. infiltrating the bony cortex.
While the majority of the lesions (60–65%) are in the cervicofacial region, some 10–20% are abdominal (usually ileocaecal) and others are in the lung (thoracic) or skin. Although most infections are monomicrobial in nature (i.e. with Actinomyces alone causing the disease), a significant proportion of infections could be polymicrobial, with other bacteria such as Aggregatibacter actinomycetemcomitans, Haemophilus spp. and anaerobes acting as co-infecting agents.
Treatment and prevention
Sensitive to penicillin, but prolonged courses up to 6 weeks are necessary for chronic infections. Oral penicillins such as amoxicillin are now popular. Recalcitrant lesions respond well to tetracycline because of its good bone penetration. Surgical intervention may be necessary in chronic jaw lesions.
Prevention of these infections is difficult because of their endogenous nature.
Nocardia
Nocardia species are soil saprophytes and cause nocardiosis in humans, especially in immunocompromised patients. These organisms are aerobic, Gram-positive rods, which form thin, branching filaments. Nocardia asteroides causes the most common form of human nocardiosis, which is essentially a pulmonary infection that progresses to form abscesses and sinus tracts.
Clostridia
Clostridia comprise many species of Gram-positive, anaerobic spore-forming bacilli (but spores are not found in infected tissues); a few are aerotolerant. They are an important group of pathogens widely distributed in soil and in the gut of humans and animals. There are four medically important species (Clostridium tetani, Clostridium botulinum, Clostridium welchii and Clostridium difficile) that cause significant morbidity and mortality, especially in developing countries. The major diseases caused by these organisms are listed in Table 13.1.
Table 13.1 Common Clostridium species associated with human disease
| Clostridium spp. | Disease |
|---|---|
| C. welchii | Gas gangrene, food poisoning, bacteraemia, soft-tissue infections |
| C. tetani | Tetanus |
| C. botulinum | Botulism (foodborne, infant, wound) |
| C. difficile | Pseudomembranous colitis, antibiotic-associated diarrhoea |
| Other species (e.g. C. septicum, C. ramosum, C. novyi, C. bifermentans) |
Bacteraemia, gas gangrene, soft-tissue infections |
Clostridium spp.
Characteristics
Gram-positive rods, but older cultures may stain irregularly. All species form characteristic endospores, which create a bulge in the bacterial body, for instance, the drumstick-shaped C. tetani (this shape is useful in laboratory identification of the organisms). Some species are motile with peritrichous flagella (e.g. C. tetani), while others (e.g. C. welchii) have a capsule.
Culture and identification
Grow anaerobically on blood agar or Robertson’s cooked meat medium (liquid culture). Although C. tetani and Clostridium novyi are strict anaerobes, Clostridium histolyticum and C. welchii can grow in the presence of limited amounts of oxygen (aerotolerant). The saccharolytic, proteolytic and toxigenic potentials of the organisms are useful in identification.
Clostridium welchii
Habitat and transmission
Spores are found in the soil, and vegetative cells are normal flora of the colon and vagina. This bacterium causes two discrete diseases, due to either exogenous or endogenous infection:
Characteristics
A short, fat bacillus. Spores are not usually found as they are formed under nutritionally deficient conditions. More tolerant of oxygen than other clostridia.
Toxins
A variety of toxins (at least 12), including collagenase, proteinase and hyaluronidase, are formed, the most notable of which is the α-toxin, which lyses the phospholipids of eukaryotic cell membranes (i.e. a phospholipase). C. welchii is divided into five types (A–E) on the basis of toxins formed; type A is the human pathogen.
Culture and identification
Grows well on blood agar under anaerobic conditions, producing β-haemolytic colonies; some are non-haemolytic. The saccharolytic characteristic is used for identification purposes as it ferments litmus milk, producing acids and gases responsible for the so-called ‘stormy-clot’ reaction.
Nagler’s reaction
The neutralization of the α-toxin of the organism growing on agar plates by a specific antitoxin is useful in identification. In this test, the organism is streaked on an agar plate containing egg yolk (which contains high concentrations of phospholipase), half of the plate having been spread with antitoxin; an opaque reaction develops, surrounding the growth of C. welchii in the untreated half of the plate, while in the other half, no such reaction occurs as the toxin is neutralized by the antitoxin (Fig. 13.3).
Fig. 13.3 Nagler’s reaction: when Clostridium welchii is grown in a medium containing egg yolk (lecithin), the enzyme (lecithinase) activity can be detected as opacity around the line of growth. On the right of the plate, no opacity develops, as antitoxin previously applied to this half of the plate has neutralized the toxin. A positive control (top arrow) and a test sample, which is also positive (bottom), are shown.
Pathogenicity
Causes gas gangrene and food poisoning.
Gas gangrene (myonecrosis)
Wounds associated with traumatized tissue (especially muscle) may become infected with C. welchii and other clostridia, with severe, life-threatening spreading infection. Activity of the bacillus in injured tissue results in toxin and enzyme production, allowing the organism to establish and multiply in the wound. Characteristic signs and symptoms include pain, oedema and crepitation produced by gas in tissues.
Food poisoning
Some strains of C. welchii produce an enterotoxin that induces food poisoning. This is due to the ingestion of large numbers of vegetative cells from contaminated food, which then sporulate in the gut and release enterotoxin. The disease is characterized by watery diarrhoea with little vomiting.
Clostridium tetani
Habitat and transmission
C. tetani is present in the intestinal tract of herbivores, and spores are widespread in soil. Germination of spores is promoted by poor blood supply and necrotic tissue and debris in wounds.
Characteristics
Long, thin bacilli with terminal spores giving the characteristic ‘drumstick’ appearance. Produces an extremely potent neurotoxin, tetanospasmin, by vegetative cells at the wound site. Another less powerful toxin, tetanolysin, is haemolytic in nature.
Culture and identification
Grows on blood agar, anaerobically, as a fine spreading colony. Identification in vitro is by a toxin neutralization test on blood agar, or in vivo by inoculation of culture filtrate into mice. The ‘two-mouse model’ is used: one animal is protected with antitoxin and the other is unprotected; the latter dies with typical tetanic spasms.
Pathogenicity
The agent of tetanus (lockjaw), which is a typical toxin-mediated disease. The powerful, heat-labile neurotoxin (tetanospasmin) is produced at the wound site and released during cell lysis (Fig. 13.4). It is retrogradely carried via the peripheral nerves (intra-axonally) to the central nervous system where it blocks inhibitory mediators at spinal synapses. This causes sustained muscle spasm and the characteristic signs of spasm of jaw muscles (lockjaw, trismus) and facial muscles (risus sardonicus), and arching of the body (opisthotonos). Toxin genes are plasmid-coded. C. tetani also produces an oxygen-labile haemolysin (tetanolysin); the clinical significance of this enzyme is not clear.
Treatment and prevention
Antitoxin (hyperimmune human α-globulin) administered with or without toxoid, depending on the immunization history of the patient. Prevention is by tetanus toxoid (a component of the diphtheria–tetanus–pertussis (DTP) vaccine) with boosters every 10 years (see Chapter 37). Proper wound debridement and administration of penicillin (to inhibit clostridial growth and secondary infection) are other important management measures.
Clostridium difficile
Found in the faeces of 3–6% adults and almost all healthy infants, C. difficile is the agent of antibiotic-associated colitis, which may lead to sometimes lethal pseudomembranous colitis. It multiplies in the gut under the selective pressure of antibiotics. Although clindamycin was earlier singled out as the main cause of colitis, it is now known that common drugs such as ampicillin may occasionally precipitate the disease. Treatment is to withhold the offending antibiotic and administer oral vancomycin or metronidazole.
As much as 25% of the common antibiotic-associated diarrhoea is considered to be due to C. difficile.
A note on Clostridium botulinum
The agent of botulism, a form of food poisoning, has powerful toxins that can be used in bioterrorism and warfare. In contrast, minute doses of botulinum toxin, injected periodically, are popular in beauty therapy as facial muscle relaxants to minimize wrinkles for a youthful appearance, so-called botox treatment utilized in aesthetic dentistry in some parts of the world.
Bacillus species
The genus Bacillus comprises nearly 50 species of sporing, Gram-positive, chain-forming bacilli. Most are soil saprophytes. Two species, Bacillus anthracis and Bacillus cereus, cause significant morbidity.
Bacillus anthracis
Spores of B. anthracis can survive in soil for years. Humans are accidental hosts, and infection (anthrax) is acquired when spores enter abrasions on the skin or are inhaled. Infection causes septicaemia and death; pulmonary anthrax (woolsorters’ disease) is a life-threatening pneumonia caused by inhalation of spores. The polyglutamic acid capsule of the organism is antiphagocytic. Recently, the organism has received much attention due to the likelihood of the use of the anthrax spores in biological warfare and bioterrorism.
Bacillus cereus
B. cereus causes food poisoning, especially when reheated, contaminated rice is eaten (particularly in restaurants serving rice-based dishes).
Bacillus stearothermophilus and Bacillus subtilis
These are used as biological indicators to test the sterilization efficacy of autoclaves, ethylene oxide and ionizing radiation (see Chapter 37).
Key facts
Drobniewski F.A. Bacillus cereus and related species. Clinical Microbiology Reviews. 1993;6:324-338.
Greenwood D., Slack R., Peutherer J., editors. Medical microbiology, 16th ed, Edinburgh: Churchill Livingstone, 2003. Chs 21–23
Hatheway C.L. Toxigenic clostridia. Clinical Microbiology Reviews. 1990;3:66-98.
Schaal K.P., Lee H.J. Actinomycete infections in humans – A review. Gene. 1995;115:201-211.
Review questions (answers on p. 352)
Please indicate which answers are true, and which are false.

